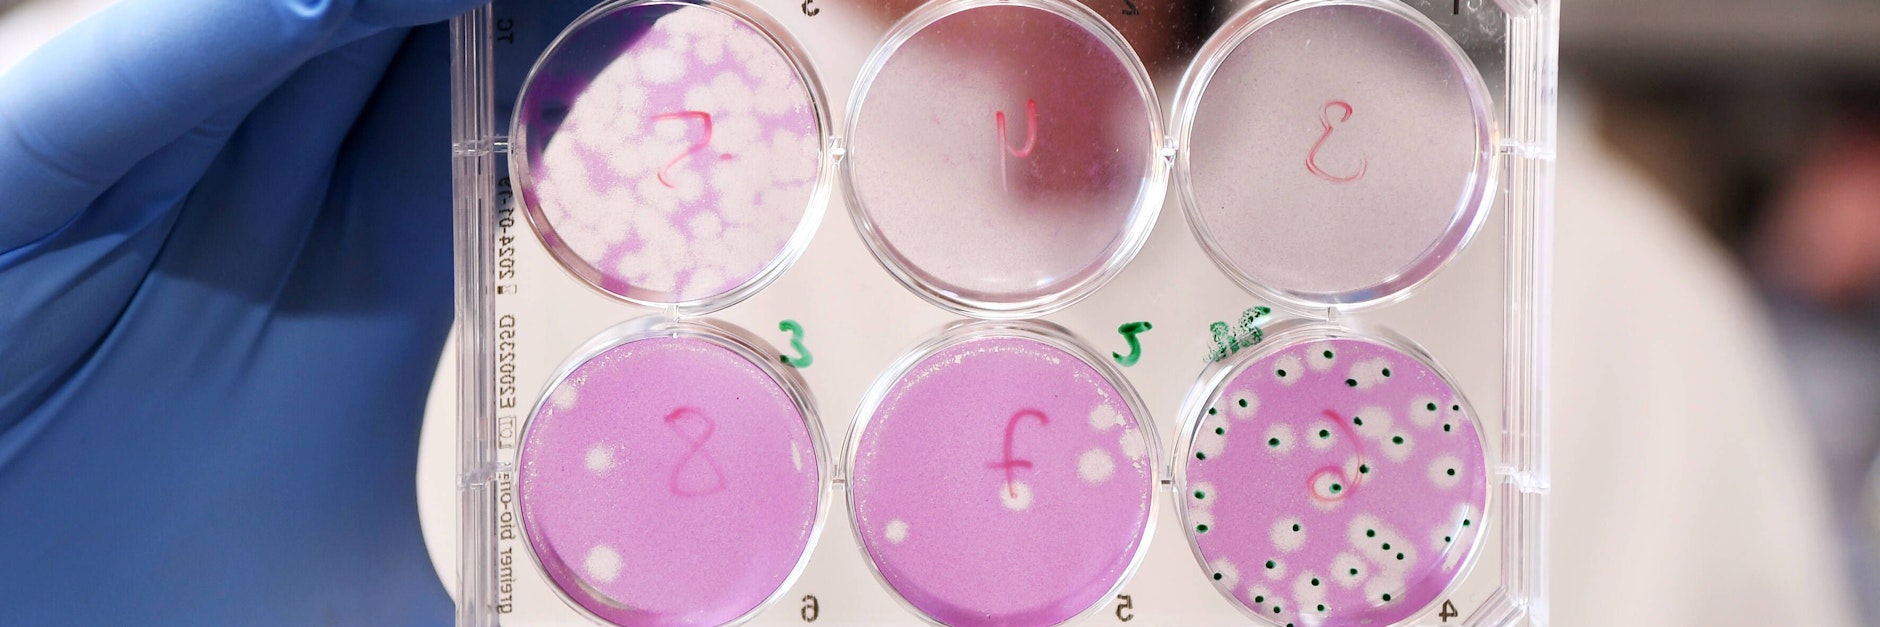
Ein Forscher hält eine Virenkultur in die Kamera (Symbolfoto).

Die gezielte Infektion von Probanden zur Erforschung eines Virus ist unter Forschern umstrittenen. Doch vom Zeitdruck getriebene Wissenschaftler nutzen diese Methode in der Corona-Pandemie nun bereits zum wiederholten Male: Britische Forscher wollen junge Menschen mit überstandener Corona-Infektion dem Virus gezielt erneut aussetzen, um die Reaktion des Immunsystems zu erforschen.
Ziel ist es, herauszufinden, welche Virusmenge für eine erneute Infektion erforderlich ist, wie das Immunsystem reagiert und was dies für die Entwicklung einer Immunität gegen den Erreger bedeutet. Bereits seit März läuft in London eine ähnliche Studie, bei der Freiwillige dem Virus gezielt ausgesetzt werden.
Die Studie soll noch im April beginnen
Die Analysen sollen nach Regierungsangaben dazu beitragen, die Entwicklung von Corona-Impfstoffen und -Medikamenten zu verbessern und zu beschleunigen. Die neue sogenannte Human-Challenge-Studie soll noch in diesem Monat beginnen. Die Teilnehmer werden in einer „sicheren und überwachten Umgebung“ dem Virus ausgesetzt und von einem Expertenteam begleitet. Gesucht werden junge, gesunde Menschen zwischen 18 und 30 Jahren, die schon einmal mit Sars-CoV-2 infiziert waren, wie die gemeinnützige Stiftung Wellcome Trust und die Universität Oxford am Montag mitteilten.
Human-Challenge-Studien seien eine wichtige Hilfe für Wissenschaftler, sagte die Impfexpertin Helen McShane von der Universität Oxford. Die erneute Infektion lasse Rückschlüsse darauf zu, wie das Immunsystem auf die erste Corona-Infektion reagierte und wie es zur erneuten Ansteckung kommt. Dies könne etwa bei der Einschätzung helfen, wie gut Menschen nach überstandener Sars-CoV-2-Infektion gegen eine erneute Ansteckung geschützt sind. Als Aufwandsentschädigung erhalten die Probanden je knapp 5000 Pfund (rund 5770 Euro).
Lesen Sie auch: Neues Schreckgespenst: Werden Coronaviren jetzt immun gegen das Impfen? >>